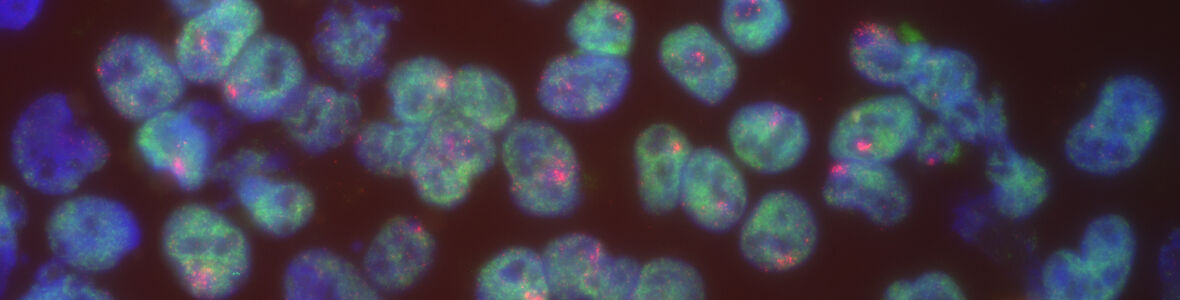

Other Program Information
Advising | Academic Standards | Transfer of Credit | Transferring into CAMB | Terminal Master's Degree
Advising
All first- and second-year Ph.D. students, and third-year combined-degree students who are in their graduate course year, will meet with a program advisor prior to each semester. The Advisor and Program Chair are responsible for approving the student's class, seminar, laboratory rotation, and/or independent study selections each semester. Any exemptions from the outlined course of study must be approved in writing by the relevant Program Chair. All course registrations must be done by the CAMB program coordinators.
Advising | Academic Standards | Transfer of Credit | Transferring into CAMB | Terminal Master's Degree
Academic Standards
The University standard for satisfactory academic progress is a 3.0 grade point average. The minimum standard for final course grades in the CAMB Graduate Group is a "B-". A CAMB student who does not achieve the minimum grade for courses will be referred to the Biomedical Graduate Studies Academic Standards Committee. The Academic Standards Committee will consider the recommendations of the Program Chair, and may place the student on academic probation. In addition, the student may be required to repeat an examination or an entire course, may be dismissed from the program, or may be allowed to continue course work towards the terminal Master's Degree. The CAMB Executive Committee will review each recommendation for student dismissal, and it is the responsibility of the Executive Committee to determine if dismissal from the program is appropriate and necessary.
A student may also be dismissed from the program for failing to make adequate effort in their thesis work, as documented by the thesis committee. Dismissal must be recommended by the thesis advisor and thesis committee, and will be reviewed by the program chair. The program chair will bring this issue to the CAMB Executive Committee for consideration, and it is the responsibility of the Executive Committee to determine if dismissal from the program is appropriate and necessary.
A student may also be dismissed from the program for engaging in academic or research misconduct, or engaging in illegal, fraudulent or unethical behavior. In these cases, dismissal will be subject to published Perelman School of Medicine and University policies and procedures, and may occur at any time during a student's work toward the doctoral degree.
Advising | Academic Standards | Transfer of Credit | Transferring into CAMB | Terminal Master's Degree
Transfer of Credit
Students who have completed graduate work at other graduate institutions may apply to transfer up to eight course units toward the Ph.D. degree. Students who have taken graduate courses at Penn through the College of Liberal and Professional Studies (LPS) may apply to transfer up to four course units toward the PhD degree. Courses below a "B" grade will not be considered for credit toward the Penn degree. According to University policy, courses will not be transferred until after a student has completed one academic year of course work in the program.
Advising | Academic Standards | Transfer of Credit | Transferring into CAMB | Terminal Master's Degree
Transferring into the CAMB Graduate Group
Penn students who are currently enrolled in another graduate group within BGS may transfer into the CAMB Graduate Group. Students should express their interest in joining the CAMB Graduate Group by writing a letter of intent to the Graduate Group Chair. The student will then meet individually with the Graduate Group Chair to discuss any issues related to fulfilling the Graduate Group and program course requirements. Following this meeting, the Graduate Group Chair will decide if the student is in good academic standing and if the student's academic interests and goals are appropriate for the CAMB program. The Graduate Group Chair, in consultation with the Program Chair of the student's program of interest, will provide the student with a written statement of required course work. The student should have the chair of the former graduate group sign a "Change of Graduate Group Form" (found on the BGS Current Students page under Forms) to release the student from the former graduate group and then have the CAMB Graduate Group Chair and their new Program Chair sign the same form to accept the student into CAMB. The CAMB Graduate Group Office will request that the student's academic file be transferred from the former graduate group office.
Advising | Academic Standards | Transfer of Credit | Transferring into CAMB | Terminal Master's Degree
Terminal Master's Degree
The Graduate Group does not admit students for study towards a Master's degree. However, the Graduate Group may award a terminal Master's degree to students who choose not to continue in the program for the PhD degree or to students who fail to pass the preliminary examination or complete their dissertation research.
These CAMB mandated requirements are in addition to conditions imposed by BGS for a terminal master’s degree.
- Students must have 18 credits completed
- Student must have a grade of B- or better in their core courses (BIOM 600, BIOM 555, BIOM 611, and CAMB 605)
- Students must submit a paper on their research acceptable to both their PI and Program Chair
- Written prelim proposal is acceptable, in lieu of the paper, with signature of PI and Program Chair